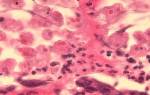

Человек, который знает, из чего состоят энергетики, вряд ли удивиться информации о том, что они наносят вред организму. Но тогда почему их продают в свободном доступе даже для подростков? Все просто.
Сами по себе вещества, которые находятся в составе, не оказывают пагубного воздействия. Смерть от энергетических напитков наступает, если употребление имеет регулярный характер или единоразово была выпита доза, которая провоцирует летальный исход.
К тому же энергетические напитки плотно укоренились на полках рядом с алкогольной продукцией. А гремучая смесь кофеина, таурина и этилового спирта — отдельная история, причем не всегда с хорошим концом.
Из чего состоят энергетики
Бодрящее действие после приема одной баночки такого коктейля вполне легко объясняется.
Ингредиенты подобраны таким образом, чтобы повлиять максимально быстро и эффективно.
Однако организмы все разные, а энергетическая жидкость выпускается в стандартных объемах. Именно этим объясняется частые передозировки напитком.
Состав стандартного энергетического коктейля:
- стимуляторы нервной системы синтетического происхождения (одним из основных компонентов является кофеин или гуарана);
- вещества, помогающие максимально быстро продуцировать организму энергию (сахар, глюкоза и т. д.);
- компоненты, которые ускоряют обмен веществ (таурин).
Красители и ароматизаторы – тоже частые ингредиенты, входящие в состав многих энергетиков. Зачастую эти вещества искусственные или идентичные натуральным, что не является полезным.
Витамины, которые составляют наименьшую часть состава, несут в себе скрытый смысл. Человек, который видит на банке информацию о витаминном комплексе, априори начинает считать продукт полезным для здоровья. Но добавлены они в энергетик совсем не для этого.
Витамины в энергетическом напитке позволяют ускорить обмен веществ, чтобы удалось открыть внутренние резервы организма.
Однако наиболее часто отравление энергетическими напитками происходит в тех случаях, когда они являются алкогольными. Во время веселой вечеринки трудно контролировать количество выпитого алкоголя. Из-за этого происходит серьезная передозировка, которая нередко приводит к смерти.
Врачи предупреждают о серьезных рисках, связанных с передозировкой энергетическими напитками. Эти напитки содержат высокие уровни кофеина и других стимуляторов, которые могут вызывать учащенное сердцебиение, повышенное давление и даже аритмии. Специалисты отмечают, что чрезмерное употребление может привести к нервозности, бессоннице и тревожности. Особенно опасно сочетание энергетиков с алкоголем, так как это может маскировать симптомы опьянения и увеличивать риск отравления. Врачи рекомендуют ограничить потребление таких напитков и обращать внимание на собственное состояние, чтобы избежать негативных последствий для здоровья.

Влияние энергетиков на организм человека
Человек, который перепил энергетиков, сначала чувствует бодрость и подъем сил.
Но постепенно, когда через слизистую ЖКТ всасывается все больше вредных веществ, наблюдаются признаки передозировки.
Одна баночка такого коктейля равнозначна единоразово заваренной и выпитой 200-граммовой пачке крепкого кофе.
Энергетики не поставляют в организм дополнительные силы, как принято считать. Энергия добывается из организма насильственным путем. Каждый из ингредиентов коктейля несет определенную функцию. Из-за их воздействия тело вынуждено находить дополнительные силы.
Все это происходит в ущерб здоровью внутренних органов, особенно сердца, которому приходится работать на износ. К тому же организм теряет большое количество жидкости, необходимой для переработки кофеина. Впоследствии это нарушает все обменные процессы.
Смертельная доза
Смертельная доза энергетика, который содержит кофеин, составляет не менее 70 полулитровых банок для человека с весом 70 кг. Однако признаки отравления могут наблюдаться и после двух баночек. Все зависит от здоровья организма, наличия или отсутствие хронических заболеваний и прочих факторов.
Смертельная доза кофеина для человека составляет 10-15г.
Мнения людей о передозировке энергетическими напитками варьируются от настороженности до полного недоверия к их безопасности. Многие отмечают, что чрезмерное употребление таких напитков может привести к серьезным проблемам со здоровьем, включая сердечно-сосудистые заболевания, бессонницу и нервные расстройства. Некоторые пользователи делятся личными историями о том, как после нескольких банок ощутили сильное сердцебиение и тревожность. В то же время, есть и те, кто считает, что при разумном подходе энергетики могут быть полезны для повышения работоспособности и концентрации. Однако большинство согласны с тем, что важно соблюдать меру и внимательно относиться к своему организму, особенно если речь идет о сочетании с другими стимуляторами или физической нагрузкой. В конечном итоге, осознанность и информированность о возможных рисках остаются ключевыми аспектами в обсуждении этой темы.

Кому они запрещены
Однако вышеописанные стандарты подходят для среднестатистического, а главное, здорового человеческого организма. Энергетики имеют несколько противопоказаний к употреблению. Лицам, которые относятся к группе риска, категорически запрещено употреблять коктейли.
Кому не рекомендуется пить энергетические напитки:
- беременным женщинам, кормящим матерям;
- несовершеннолетним детям;
- людям преклонного возраста;
- лицам, которые имеют заболевания сердечно-сосудистой системы, печени и почек;
- при сахарном диабете;
- при аллергии, бронхиальной астме.
Также специалисты не рекомендуют употреблять за раз более 500 мл напитка в сутки. Ежедневный прием тоже не пойдет на пользу. Перед тем как выпить пару баночек такой жидкости, лучше убедиться в отсутствии хронических заболеваний.
Симптомы отравления
Передозировка энергетиками отличается выраженностью и длительностью симптоматики. Изначально пострадавший может не чувствовать каких-либо отклонений в работе внутренних органов, но по мере всасывания действующих веществ из желудка в кровь симптомы отравления будут усиливаться.
Какие признаки появляются из-за передозировки коктейлем:
- тремор рук или всего организма;
- головная боль;
- тошнота, рвота;
- нарушение координации движений;
- резкое повышение артериального давления, учащение сердцебиения;
- гиперемия лица;
- потеря сознания;
- нервные проявления.
При передозировке энергетиком, который содержит этиловый спирт, помимо всех признаков, у пациента наблюдается неадекватное поведение, полное или частичное отсутствие сознания.
Однако проблемы со здоровьем наблюдаются не только у тех лиц, которые однократно злоупотребили большой дозой кофейного напитка.
Если человек принимает энергетические коктейли на регулярной основе, у него также может проявляться ряд проблем со здоровьем. Как правило, у таких лиц диагностируются заболевания органов сердечно-сосудистой системы, нарушение работы пищеварительного тракта и нервные расстройства.

Лечение
Если у пострадавшего наблюдаются признаки сильной передозировки, ему обязательно должны оказать первую помощь, после чего проконсультироваться с врачом. Особенно это необходимо в том случае, если человек находится в алкогольном опьянении.
Первая помощь:
- Больного уложить на горизонтальную поверхность, расстегнуть все верхние пуговицы на одежде. Обеспечить приток свежего воздуха. Для этого следует открыть окно.
- Дать выпить пострадавшему не менее 2 литров воды, с разведенной в ней марганцовкой. Впоследствии вызвать рвоту, надавливая на корень языка столовой ложкой.
- Когда основная часть коктейлей вышла из организма вместе с рвотой, пациент должен выпить кишечный сорбент, следуя инструкции на упаковке. Это может быть уголь, смекта, полисорб или любое другое подручное средство.
- Вызвать скорую медицинскую помощь и до приезда врача следить, чтобы человек не потерял сознание.
Запрещено давать пострадавшему какие-либо лекарства. Особенно это касается сердечных медикаментов и препаратов, снижающих артериальное давление. Неправильный подбор и дозировка средства способна вызвать шок, коллапс или остановку сердца.
Чтобы предотвратить отравление энергетическими напитками, их следует употреблять умеренно и только при крайней необходимости. Ни в коем случае это не следует делать на голодный желудок.
Чтобы чувствовать себя хорошо, человеку нужно высыпаться. Все остальные средства для бодрости оказывают лишь временный эффект, к тому же очень пагубный для организма.
Вопрос-ответ
Как понять, что передозировка от энергетика?
Симптомы отравления энергетиком: ⇒ учащение ритма сердца, ⇒ бессонница, ⇒ повышение давления в артериях, ⇒ покраснение щек, шеи и лба, ⇒ нервозность, ⇒ расстройство работы пищеварительного тракта (боли в желудке), ⇒ дрожание рук и пальцев, ⇒ проблемы с координацией движений.
Что будет от передозировки энергетика?
Передозировка выражается нервозностью, апатией и депрессией, психическим возбуждением, хроническим нарушением сердечного ритма. Смешивание энергетических напитков с другими энергетиками, которые содержат кофеин, может привести к непредсказуемым последствиям.
Что делать, если выпил слишком много энергетиков?
Поняв, что произошла передозировка энергетика, следует прекратить его употребление и выйти на свежий воздух. Если тошнит, надо принять активированный уголь и вызвать рвоту. Можно нейтрализовать кофеин, выпив молоко или сливки, приняв пищу с высоким содержанием магния (он есть в капусте, фасоли, авокадо).
Какая доза энергетика опасна?
Для человека смертельной дозой являются 100 или 150 чашек кофе в день в зависимости от строения и массы тела (это 10—15 г кофеина) [3, 16].
Советы
СОВЕТ №1
Изучите состав энергетических напитков перед их употреблением. Обратите внимание на содержание кофеина, сахара и других стимуляторов. Это поможет вам избежать нежелательных эффектов и определить безопасную для себя дозу.
СОВЕТ №2
Ограничьте потребление энергетических напитков. Рекомендуется не превышать 1-2 банок в день, особенно если вы чувствительны к кофеину или имеете проблемы с сердечно-сосудистой системой.
СОВЕТ №3
Не используйте энергетические напитки как замену полноценного сна или отдыха. Если вы чувствуете усталость, лучше отдохните или займитесь физической активностью, чтобы восстановить силы естественным образом.
СОВЕТ №4
Обратите внимание на свои ощущения после употребления энергетических напитков. Если вы заметили учащенное сердцебиение, головные боли или другие неприятные симптомы, прекратите их употребление и проконсультируйтесь с врачом.